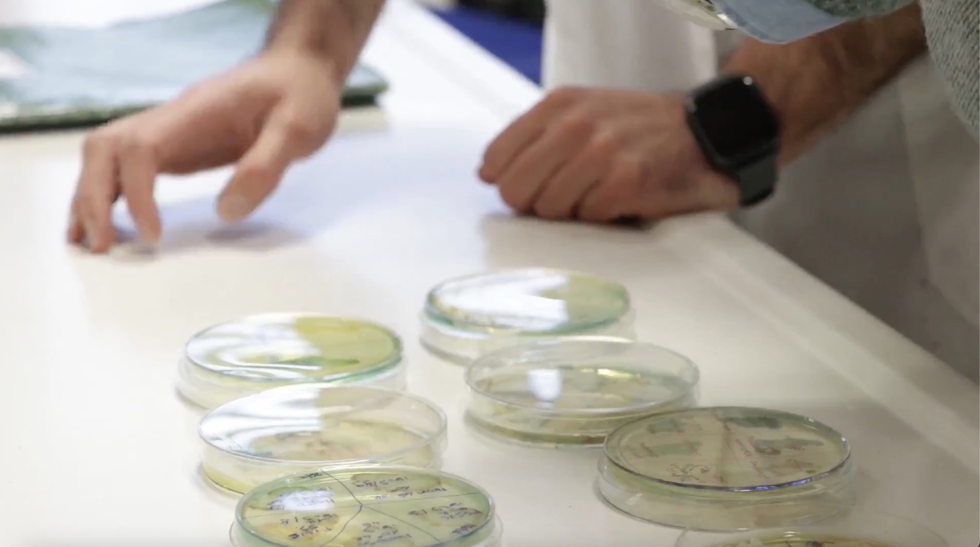
Imagen

La bioacidificación de mostos, herramientas innovadoras para la preservación de la acidez y la elaboración de vinos de calidad
La maduración de la uva tiene lugar cada vez de forma más rápida y acelerada, con un mayor incremento de la concentración de azúcares y mayor disminución de la concentración de ácido málico, siendo este el segundo ácido más importante de la uva y del vino después del ácido tartárico. El desfase entre la maduración tecnológica relacionada con el incremento de azúcares y disminución de acidez con la maduración fenólica relacionada con la concentración de polifenoles ubicados en la piel y semillas de la uva, o bien la maduración aromática de las variedades donde predominan los tioles y terpenos son claros indicadores de maduraciones rápidas. De forma directamente proporcional, la disminución de la acidez está ligada también a un incremento de los valores de pH estrechamente relacionado con la sensibilidad a la oxidación de los vinos y a la inestabilidad microbiológica. Y es que la acidez del vino, no únicamente está relacionada con la sensación gustativa de volumen y estructura sino que también está relacionado con colores más brillantes, perfiles aromáticos más frescos, resistencia a la inestabilidad microbiológica, mayor resistencia a la oxidación y mayor capacidad de crianza.
Los viticultores pueden emplear estrategias vitícolas para la preservación de la acidez, como selección de nuevas variedades y portainjertos, cambios en la gestión del suelo y de la vegetación, cambios en la fecha de vendimia o directamente cultivo en nuevas zonas más elevadas y frescas, algunas de estas prácticas obviamente no siempre son posibles y su implantación no es inmediata. En este contexto, las soluciones más tangibles y aplicables para la preservación de la acidez, son las soluciones enológicas que se llevan a cabo en bodega, y entre estas destacamos las técnicas de bioacidificación, mediante el uso de microorganismos, principalmente levaduras Saccharomyces y no-Saccharomyces.
En Wine Improve somos especialistas en productos enológicos y soluciones de vanguardia para la resolución de problemas del sector y la elaboración de grandes vinos a través de herramientas biotecnológicas. Entre ellas, y relacionadas con la preservación de la acidez, destacan el uso de levaduras en crema ATECREM con gran capacidad de acidificación y el de las levaduras Lachancea thermotolerans con capacidad de acidificación de mostos y vinos a partir del a generación de ácido láctico.
Las levaduras en crema ATECREM ideadas y fabricadas por Bioenologia 2.0, y comercializadas en España por Wine Improve, presentan múltiples funcionalidades para la elaboración de una amplia tipología de vinos de calidad. A parte de caracterizarse por elaborar vinos con un elevado poder antioxidante, justificado por la elevada cesión de moléculas antioxidantes, principalmente glutatión, que se genera hasta 28 veces más que en las LSA, mejora de las características organolépticas incrementando la tipicidad y expresión de los vinos y mejora de las sensaciones gustativas, destacan también por su poder acidificante natural gracias a la bomba protónica que les permite liberar protones en el medio incrementando la acidez de los vinos al mismo tiempo que capta potasio del medio. En las últimas pruebas llevadas a cabo la pasada vendimia 2024, mostraron resultados de incremento de acidez total tartárica entre 0,8 y 1,4 en vinos tintos y 0,5 y 1,0 en vinos blancos. Estos incrementos de acidez adicionalmente están asociados a una disminución de pH de entre 0,36 y 0,23 unidades en vinos tintos (Figura 1).

Para la completa activación de la bomba protónica de las levaduras en crema y maximización de todo su potencial de bioacidificación es recomendable el uso de nutrición específica basada en Lysopol, autolisado de levadura para la estimulación natural caracterizado por un alto contenido en vitaminas del grupo B y Probios Liquid, que aporta a las levaduras una nutrición perfectamente equilibrada durante todo el proceso de fermentación aportando nitrógeno fácilmente asimilable y especialmente indicado para la activación de la bomba protónica.
De forma adicional a las levaduras en crema, la levadura no-Sacchacromyces crerevisiae, K-ACID, preparada de la mano de LEV2050 a partir de Lachancea thermotolerans es una excelente estrategia para la preservación de la acidez en mostos y elaboración de vinos deficientes de acidez. Esta estrategia se basa en la capacidad de la levadura para la generación de ácido láctico de hasta 12 g/l. Esta generación puede potenciarse mediante la preparación de su cultivo mediante biorreactor. Su uso puede ser con la totalidad del mosto a tratar, siguiendo la evolución del pH en bodegas hasta conseguir el valor deseado e inocular otras levaduras con capacidad fermentativa o bien para la acidificación total de un mosto y posterior mezcla con los mostos a acidificar. En esta segunda opción se recomienda utilizar K-ACID en porcentajes bajos según el perfil del vino deseado (entre un 3 y 8% de la mezcla acidificada).
Las soluciones de bioacidificación propuestas, conforman herramientas útiles y naturales para la preservación e incremento de acidez en la elaboración de vinos de calidad, para la potenciación de las cualidades organolépticas e incremento de la vida útil de los vinos.
Para más información sobre las levaduras, contacte: www.wineimprove.net.
Las levaduras en crema ATECREM y Lachancea thermotolerans de Wine Improve permiten incrementar la acidez, reducir el pH y potenciar el perfil organoléptico de los vinos, garantizando su estabilidad y longevidad










